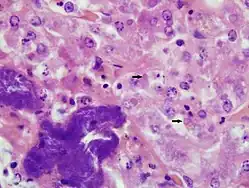
Leberpräparat einer Boa constrictor mit BIBD (HE, 1000fache Vergrößerung). Eosinophile EK in Leberzellen (ausgewählte EK mit Pfeilen markiert). Zusätzliche bakterielle Infiltration mit akuter Leberzellnekrose (dunkel gefärbte Bereiche unten links).

Einschlusskörperchenkrankheit der Riesenschlangen

Die Einschlusskörperchenkrankheit der Riesenschlangen (boid inclusion body disease BIBD, auch Einschlusskörperchenkrankheit (EK) der Boas oder Boide EK genannt) ist eine tödlich verlaufende Infektionskrankheit, die bei Boas (Boidae) und Pythons (Pythonidae) vorkommt. Die BIBD gilt heute auch aufgrund der sich mehrenden Fälle als wichtigste Infektionskrankheit bei Schlangen in Gefangenschaft. Sie konnte zuerst Ende der 1970er Jahre bei Tieren in privaten Sammlungen und in zoologischen Gärten der Vereinigten Staaten, später auch in Afrika und Europa beobachtet werden.[1][2] Als Krankheitserreger waren seit 1994 Retroviren in den Fokus geraten, da in den Zellen fast aller infizierten Organe der Tiere neben den typischen Einschlusskörperchen auch virusähnliche Partikel vom retroviralen C-Typ gefunden wurden. Dies hat sich in weiteren Studien als nicht haltbar erwiesen. Seit 2012 wird eine Virusinfektion mit verschiedenen neu entdeckten Viren der Gattung Reptarenavirus (Familie Arenaviridae) als Krankheitsursache angenommen. Diese neu entstandenen Viren sind sehr wahrscheinlich als sogenannte Emerging Viruses genetische Neukombinationen und Varianten von zuvor nicht krankheitsauslösenden Arenaviren bei Schlangen.
Die Virusinfektion verläuft bei erwachsenen Schlangen schleichend, chronisch und in den ersten Wochen und Monaten mit keiner oder nur sehr geringer klinischer Symptomatik. In dieser Zeit kann es sehr wahrscheinlich durch Schmierinfektion von Tier zu Tier oder durch Kontakt mit infizierten Gegenständen zur Übertragung auf weitere Tiere kommen. Bei Boas ist auch eine Übertragung durch das Muttertier auf die Jungtiere möglich. Eine Übertragung durch Schlangenmilben (Ophionyssus natricis) als Vektor wird ebenfalls diskutiert. Die erkrankten Schlangen sterben an schweren neurologischen Störungen, die eine Nahrungsaufnahme verhindern. Da weder eine spezifische antivirale Therapie noch eine vorbeugende Impfung verfügbar sind, bestehen die einzig verfügbaren Maßnahmen zur Eindämmung der Infektion in einer strikten drei- bis sechsmonatigen Quarantäne, Einhaltung der Hygiene bei der Haltung (Desinfektion von Gegenständen und Händen) sowie der Tötung erkrankter Tiere. Eine strikte Isolierung infizierter, aber noch nicht erkrankter Tiere ist möglich.
Ätiologie
Histopathologie
-
Leberpräparat einer Boa constrictor mit BIBD (HE, 1000fache Vergrößerung). Eosinophile EK in Leberzellen (ausgewählte EK mit Pfeilen markiert). Zusätzliche bakterielle Infiltration mit akuter Leberzellnekrose (dunkel gefärbte Bereiche unten links).
Leberpräparat einer Boa constrictor mit BIBD (HE, 1000fache Vergrößerung). Eosinophile EK in Leberzellen (ausgewählte EK mit Pfeilen markiert). Zusätzliche bakterielle Infiltration mit akuter Leberzellnekrose (dunkel gefärbte Bereiche unten links). -
 Immunhistochemisches Präparat der Bauchspeicheldrüse einer Boa constrictor mit BIBD: EK dunkelrot mit monoklonalen Anti-IBD-Protein-Antikörpern gefärbt (Pfeile), Zellkerne blau gegengefärbt, Balken 20 µm (L.-W. Chang et al. 2013).
Immunhistochemisches Präparat der Bauchspeicheldrüse einer Boa constrictor mit BIBD: EK dunkelrot mit monoklonalen Anti-IBD-Protein-Antikörpern gefärbt (Pfeile), Zellkerne blau gegengefärbt, Balken 20 µm (L.-W. Chang et al. 2013).

Als besonderes histologisches Merkmal fielen bei den ersten Fallbeschreibungen der BIBD die sogenannten Einschlusskörperchen (EK) auf. Man fand sie in ganz unterschiedlichen Zelltypen fast aller Organe, bei Boas in sehr hoher Zahl in Epithelzellen aller Organe des Gastrointestinaltraktes (einschließlich Bauchspeicheldrüse, Leber, Tonsillen der Speiseröhre), im Epithel des Atemtraktes und der Nierenkanälchen sowie in Nervenzellen des Zentralnervensystems (im Unterschied zu Pythons bei Boas auch in Gliazellen).[3][4] Vermehrt nachweisbare Lymphozyten im umgebenden Gewebe sind als Zeichen einer Entzündungsreaktion nur in wenigen Fällen zu beobachten.
Die EK als histopathologische Veränderung sind charakteristisch für eine ganze Reihe verschiedener Infektionen mit intrazellulären Erregern wie Viren, so dass nach diesen ersten Befunden bereits eine den gesamten Organismus betreffende (systemische) Virusinfektion als Krankheitsursache vermutet wurde. Die bei der BIBD im Zytoplasma vorkommenden EK sind in der Hämatoxylin-Eosin-Färbung besonders intensiv mit dem sauren Farbstoff Eosin anfärbbar (eosinophil), was auf eine basophile Eigenschaft der EK hindeutet. In elektronenmikroskopischen Aufnahmen gehen die sehr dunkel (elektronendicht) erscheinenden EK von Polyribosomen aus und der Rand großer EK ist oft von einem Kranz kleinerer, sich abschnürender EK umgeben. Gelegentlich sind konzentrische Strukturen innerhalb der EK zu beobachten.[5] Als Hauptbestandteil der Einschlusskörperchen konnte ein etwa 68 kDa großes Protein identifiziert werden.[6] Spezifische Antikörper gegen dieses sogenannte IBD-Protein wurden im Blut erkrankter Schlangen nachgewiesen.[7] Mit monoklonalen Antikörpern gegen dieses Protein können die Einschlusskörperchen in immunhistologischen Färbungen von Gewebeproben spezifisch angefärbt und dargestellt werden (siehe Abbildung).
Erreger
In elektronenmikroskopischen Aufnahmen entdeckte Schumacher 1994 membranumhüllte, virusähnliche Partikel innerhalb der histologisch veränderten Zellen. Die Partikel waren 110 nm im Durchmesser groß und hatten im Inneren ein hexagonales, möglicherweise ikosaedrisches Kapsid. Außerhalb der Zelle waren diese Viruspartikel nicht zu beobachten.[8] Ähnliche Partikel fanden sich in primären Nieren-Zellkulturen erkrankter Abgottschlangen. Nach Injektion von zellfreien Überständen dieser Zellkulturen in zwei Dunkle Tigerpythons (Python molurus bivittatus) erkrankten die Tiere an BIBD und wiesen im Gewebe die typischen EK auf. Die zuvor beobachteten Partikel waren jedoch nicht mehr zu finden. Aufgrund ihrer Größe und des konzentrischen Kapsids nahm Schumacher an, dass es sich um Retroviren mit einer sogenannten C-Typ-Morphologie (Alpharetroviren) handeln könnte. Wozniak und Kollegen infizierten daraufhin gesunde Boas mit homogenisiertem Lebergewebe einer erkrankten Abgottschlange, das sie zuvor filtrierten (Porengröße bis 45 µm). Die Schlangen wiesen nach etwa zehn Wochen die typischen EK auf, die virusähnlichen Partikel waren wieder zu beobachten, jedoch zeigten die Tiere auch nach einem Jahr keinerlei Krankheitszeichen.[6] Damit waren zwei der drei Koch’schen Postulate zum Beweis eines Krankheitserregers als krankheitsauslösende Ursache nicht erfüllt. Eine spätere Untersuchung über das Vorkommen von Retroviren bei BIBD-erkrankten Schlangen konnte keinen Zusammenhang zwischen Viruspräsenz und Erkrankung aufzeigen.[9] Retroviren, besonders Endogene Retroviren, sind bei Amphibien und Reptilien häufig zu finden, auch Genomsequenzen von Endogenen Retroviren des C-Typs sind bei Reptilien weit verbreitet[10]. Obwohl Retroviren bei Schlangen in der Lage sind, Tumorerkrankungen auszulösen, können diese Viren auch ohne eine krankheitsauslösende Bedeutung in Zellen gesunder Pythons beobachtet werden. Gegen ein Retrovirus als Erreger der BIBD spricht zusätzlich, dass für diese Viren die Bildung großer zytoplasmatischer Einschlusskörperchen untypisch ist.

Die Suche nach einem Erreger erfuhr 2012 eine neue Wendung, als bei erkrankten Abgottschlangen und Ringelboas zwei Viren und eine weitere inkomplette virale Genomsequenz identifiziert wurden, die aufgrund ihrer Sequenzähnlichkeit und ihrem Genomaufbau der Familie Arenaviridae zugehörig erschienen.[11] Dies gelang mit einer moderneren Methode, der Metagenomanalyse und Sequenzierung mit einer Deep-Sequencing-Technik. Dies war der erste Nachweis von Arenaviren außerhalb von Säugetieren als Wirt. Die neuentdeckten Virusisolate wurden Golden-Gate-Virus (GGV) und California-Academy-of-Sciences-Virus (CASV) benannt. Innerhalb der Arenaviridae sind die beiden Viren deutlich von den bisherigen Gattungen verschieden, unter anderem sind die viralen Glykoproteine der Virushülle jenen der Filoviridae ähnlicher als den bisher bekannten Arenaviren. Eine weitere Arbeitsgruppe bestätigte unabhängig hiervon kurz darauf die Ergebnisse in erkrankten Abgottschlangen, in primären Zellkulturen und durch Strukturanalysen der Virionen.[12] Sie fanden ein weiteres, dem GGV und CASV sehr ähnliches Arenavirus, das Universität-Helsinki-Virus (UHV). Eine weitere Studie identifizierte im gleichen Jahr das Boa-Arenavirus NL B3 (jetzt ROUT-Virus genannt), das auf der Basis von Sequenzvergleichen dem UHV am nächsten steht.[13] Als neu zu schaffende Virusgattung schlugen die Entdecker des UHV die Virusgruppe der Boid Inclusion Body Disease-associated Arenaviruses (BIBDAV) vor, durch das International Committee on Taxonomy of Viruses wurde die neue Gattung jedoch als Reptarenavirus in die Taxonomie aufgenommen.[14]
Nach einer Aufreinigung des 68 kDa-Proteins (IBD-Protein) aus infizierten, primären Schlangenzellkulturen und einer darauf folgenden Proteinanalyse mittels Massenspektrometrie (MALDI-TOF), wurde es als virales Nukleoprotein von Reptarenaviren identifiziert.[12] Es liegt mit seiner Größe im Bereich der Nukleoproteine anderer Arenaviren (63 bis 68 kDa), die ebenfalls an Membranen zusammengelagert im Zytosol vorliegen und mit der Replikation der viralen RNA assoziiert sind.[15] Neben dieser Funktion als wichtiger Bestandteil des Replikationskomplexes (Viroplasma) macht das Nukleoprotein auch mit etwa 70 % die Hauptmasse der Virionen aus. Es ist wie alle viralen Nukleo- und Kapsidproteine basisch, was die lange bekannte eosinophile, basophile Eigenschaft der Einschlusskörperchen erklärt.
Viele weitere neue Arenaviren konnten 2015 in Abgottschlangen identifiziert und mit der BIBD in Verbindung gebracht werden.[16] Darunter waren das Universität-Gießen-Virus (UGV), Tavallinen-Suomalainen-Mies-Virus (TSMV), Hans-Kompis-Virus (HKV) und Suri-Vanera-Virus (SVaV), die alle den neuen Viren in der Gattung Reptarenavirus sehr ähnlich sind. Ein Virus, das Haartman-Institut-Schlangenvirus (HISV), fügte sich aufgrund der Sequenzanalyse jedoch nicht in diese Gattung und daher wurde vom ICTV in für diese Spezies eine weitere neue Gattung Hartmanivirus (sic!) in der Familie Arenaviridae eingerichtet. Von diesen Viren wurde jedoch nur das große der beiden Genomsegmente, das L-Segment, zur Sequenzanalyse herangezogen. Ob diese einzelnen Viren alle als eigene Arten oder nur Unterarten oder Subtypen angesprochen werden können, ist nicht abschließend geklärt.[17]
Im Vergleich zu anderen Virusinfektionen ist der Befund ungewöhnlich, dass bei Tieren mit BIBD immer eine Mischung verschiedener Reptarenaviren oder mehrere abweichende Varianten einer Virusart gleichzeitig isoliert werden. Eine Untersuchung zur Varianz, Verteilung und Übertragung dieser Viren belegte verschiedene Mechanismen, die die beobachtete Variabilität erklären können.[18] Dazu gehört ein Reassortment der beiden arenaviralen RNA-Segmente, eine intrasegmentale Rekombination zwischen gleichen Segmenten verschiedener Virusisolate und eine hohe Mutations- und Replikationsrate im neu infizierten Tier. Nach natürlicher Kontaktübertragung von einer erkrankten auf eine nichtinfizierte Schlange war im neuinfizierten Tier zunächst ein einheitlicher Virusstamm nachweisbar, der sich innerhalb weniger Wochen bis zum Ausbruch der Erkrankung in mehrere, deutlich verschiedene Virusstämme aufspaltete. Bei allen untersuchten Tieren wurden insgesamt 23 unterschiedliche Genotypen des L-Segments und 11 des S-Segments identifiziert, wobei stets nur ein S-Segment-Genotyp in einem einzelnen Tier wie auch in einer bestimmten Population von Schlangen vorherrschend war. In der überwiegenden Zahl der Fälle (77 % der Infektionen) wurde der S-Genotyp 6 nachgewiesen, der eine besonders hohe Replikationsrate oder einen optimierten Zelleintritt aufweisen könnte. Das Ausmaß der hier vorliegenden Diversität der Virusstämme und die Geschwindigkeit ihrer Neukombination ist von anderen Virusinfektionen bei Tieren und Menschen nicht bekannt.
Ursprung der viralen Erreger
Die Haltung von Riesenschlangen in Zoologischen Gärten und Wandermenagerien ist in Europa und Amerika seit dem 19. Jahrhundert bekannt, die häusliche Haltung in Terrarien von Privatleuten ist seit den 1950er Jahren zunehmend verbreitet. Trotz der langen Geschichte der Schlangenhaltung wurde vor dem Ende der 1970er Jahre von keiner Erkrankung berichtet, die dem tödlichen und charakteristischen Verlauf der BIBD ähnlich wäre.[19] Neben dem Neuauftreten einer bis dahin unbekannten Erkrankung sprechen ebenfalls virologische Eigenschaften dafür, dass die Infektion durch ein Überspringen der Erreger von einem noch unbekannten natürlichen Wirt auf in Gefangenschaft gehaltene Riesenschlangen erfolgte. Typisch für den Krankheitsverlauf eines in einer Tierpopulation neu auftretenden Virus ist seine oft noch nicht optimierte Übertragungsfähigkeit (geringe Kontagiosität), ein schwerer Krankheitsverlauf oder eine hohe Letalität sowie eine hohe Variabilität der Erreger im neuen Wirt. Begünstigt wird die Anpassung an einen neuen Wirt besonders durch eine erhöhte Populationsdichte der Wirte, die die Wahrscheinlichkeit mehrerer Übertragungen des Erregers zwischen den neuen Wirten auch bei Abwesenheit der ursprünglichen Infektionsquelle entscheidend erhöht.[20] Diese Zirkulation innerhalb der neuen Wirtspopulation kann zu einer Verbesserung der Übertragungs- und Replikationsfähigkeit (replicative fitness) neuer Viren führen und die Infektion damit dauerhaft in der neuen Wirtsspezies etablieren. Diese auch als viral traffic bezeichnete Zirkulation ist entscheidend bei der Etablierung neuer, sogenannter Emerging Viruses („neu entstehende Viren“).[21] Durch die Intensivierung des Tier-Tier-Kontaktes in Gefangenschaft größerer Tiergruppen kann neuen Erregern eine günstigere Gelegenheit zur Zirkulation geboten werden als unter natürlichen Bedingungen, da freilebende Riesenschlangen Einzelgänger sind.
Die wichtigsten Beispiele für einen solchen Wirtsübergang beim Menschen sind die Humanen Immundefizienzviren, die Henipaviren, das Influenza-A-Virus H5N1 oder das MERS-Coronavirus, beim Haustier das Canine Parvovirus 2. Arenaviren wie das Lassa-Virus oder das Lymphozytäre-Choriomeningitis-Virus (LCMV) sind aufgrund ihrer genetischen Variabilität und ihrer geringen Wirts- und Zellspezifität (Tropismus) für artübergreifende Infektionen bekannt. Beim Lassa-Virus sind Übertragungen von Nagetieren auf den Menschen möglich, wenn die Nagetiere der Ernährung dienen[22], so dass auch ein Übergang der neuen Arenaviren durch gefütterte Nagetiere auf die Riesenschlangen möglich erschien.
Die bei der BIBD isolierten Arenaviren können sich aufgrund des gering ausgeprägten Tropismus nicht nur in Zellkulturen mit Schlangen-Zelllinien vermehren, sondern auch in Säugetierzellen.[23] Bei dieser Vermehrung des Universität-Helsinki-Virus (UHV) in Vero-Zellen (aus Grünen Meerkatzen) und in menschlichen A549-Zellen passte sich das Virus bereits nach drei Passagen an die neuen Zellen an und erhöhte seine Replikationsrate. Überraschend war der Umstand, dass die Vermehrung des UHV in Schlangen- und Säugetierzellen bei 37 °C vollständig gehemmt wird, während bei 30 °C optimale Vermehrungsbedingungen herrschen. Daraus kann gefolgert werden, dass diese Viren in ihrer Vermehrungsfähigkeit auf die Körpertemperatur von wechselwarmen Tieren wie Reptilien und Amphibien adaptiert sind. Dies würde, ebenso wie die erheblichen Unterschiede zwischen den Reptarenaviren und den bekannten Arenaviren in Säugetieren (besonders Nagetieren) im sogenannten Z-Protein und der Hüllproteine, eine Herkunft der BIBD-assoziierten Viren von anderen Säugetieren unwahrscheinlich erscheinen lassen. Als mögliche Quelle kommt theoretisch ein Eintrag über freilebende Riesenschlangen oder andere Schlangenarten in Betracht, bei denen ursprüngliche Reptarenaviren adaptiert sind und keine Infektionskrankheit auslösen, bei ihnen die Infektion also klinisch nicht erkannt wird. Ebenso sind andere Reptilien oder Amphibien, die bei der menschlichen Tierhaltung in nicht-natürlichen Kontakt mit Riesenschlangen kommen, als ursprünglicher Wirt denkbar. Der Nachweis von häufigen Reassortments und Rekombinationen des Virusgenoms lässt die Vermutung zu, dass die pathogenen Reptarenaviren am ehesten durch Neukombination ursprünglich nicht-pathogener Viren bei freilebenden Riesenschlangen entstanden.[24] Dies würde durch einen unnatürlich dichten Tierkontakt in der Haltung und das beständige Einbringen freilebender Tiere mit natürlich vorkommenden und bei Züchtern sehr beliebten Farbvarianten der Schuppenhaut (sogenannter color morphs) begünstigt. Die in der Natur möglicherweise vorkommenden Reptarenaviren könnten derselben, geographisch unterschiedlich verlaufenden Koevolution zwischen Reservoirwirt und Schlangenvirus unterliegen, wie dies von anderen Arenaviren bekannt ist und damit die Variabilität neuer Reptarenaviren durch Neukombination erhöhen. Nach Zusammenführung der Tiere in der Gefangenschaft können aus den geographisch unterschiedlichen Varianten schließlich neue, pathogene Reptarenaviren entstehen.
Übertragung

Der hauptsächliche Übertragungsweg ist noch nicht ausreichend geklärt. Sehr wahrscheinlich kommen eine direkte Schmierinfektion von Tier zu Tier und eine indirekte Übertragung durch kontaminierte Gegenstände und Hände beim Umgang mit den Schlangen in Betracht. Eine Übertragung von Muttertier zu Jungtier wird bei Boas vermutet, wobei unklar ist, ob ein enger Kontakt hierfür ausreicht oder eine echte vertikale Infektion eine Rolle spielt. Ausscheidungen wie Speichel und Erbrochenes erkrankter Tiere gelten als potentiell infektiös. Da die Ausbreitung innerhalb einer Tiergemeinschaft vergleichsweise langsam geschieht, wird eine Übertragung über die Luft als wenig wahrscheinlich angesehen. Auch weist die langsame Übertragung auf eine nicht sehr hohe Kontagiosität des Erregers hin. Auffällig ist ein gehäuftes Vorkommen der BIBD in Haltungen, die mit der blutsaugenden Schlangenmilbe Ophionyssus natricis befallen sind. Dies führte zu der Vermutung, dass diese Ektoparasiten an der Übertragung zumindest beteiligt sein könnten.[25] Ein Beweis für diese Vermutung, beispielsweise durch Nachweis der Viren im Parasit oder durch experimentelle Übertragung, wurde bislang (Stand 2016) nicht erbracht.[26] Da beide, die BIBD und der Befall mit Schlangenmilben, durch unsaubere Tierhaltungen begünstigt werden, könnte dies die beobachtete Koinzidenz ebenfalls erklären.
Die Erkrankung kann experimentell auf Schlangen übertragen werden, wenn ultrafiltrierter Zellkultur-Überstand von primären Zellkulturen aus Gewebe erkrankter Schlangen einem Versuchstier injiziert wird. Eine Übertragung mit zentrifugierten, zellfreien Organsuspensionen einer erkrankten Abgottschlange (Boa constrictor) auf Tigerpythons ist experimentell möglich.[27] Es gibt keinen Hinweis auf eine Übertragung der Reptarenaviren auf den Menschen.
Vorkommen
Die BIBD kommt nur bei Boas und Pythons vor, wobei die Häufigkeit bei Boas ungleich höher ist. Umfassende Untersuchungen zur Prävalenz liegen noch nicht vor, lediglich die Untersuchung unterschiedlich großer, meist gemeinsam in einer Einrichtung gehaltener Tiergruppen ist publiziert. Eine Post-mortem-Untersuchung in den USA wies eine Prävalenz von mehr als 33 % bei verschiedenen Unterarten der Abgottschlange und 28 % bei der Ringelboa (Corallus annulatus) auf[28], während die BIBD in den untersuchten 301 Pythons nicht nachgewiesen wurde. Sehr gering war die Prävalenz bei bodenlebenden Riesenschlangen (Acrantophis spp., Epicrates spp. und Eunectes spp.). Eine Untersuchung des Veterinäruntersuchungsamtes Ostwestfalen-Lippe konnte bei der Sektion von 575 Boidae nur bei 2 % der untersuchten Pythons, jedoch bei 47 % der Boas BIBD-typische histologische Veränderungen nachweisen.[29] Bei einer Untersuchung von 100 lebenden und klinisch zunächst unauffälligen Schlangen aus 14 verschiedenen Haltungen in Deutschland, fand sich eine BIBD bei 3 von 32 Abgottschlangen, 2 von 16 Hellen Tigerpythons oder Dunklen Tigerpythons und 1 von 4 Netzpython.[30]
Nachdem die Infektion als eigenständige Erkrankung beschrieben war, wurde sie zunächst am häufigsten beim Dunklen Tigerpython (Python molurus bivittatus) festgestellt. Die BIBD wurde dann 1998 in gefangenen Rautenpythons (Darwin-Teppichpython Morelia spilota variegata und Diamantpython Morelia spilota spilota) in Australien[31], in Abgottschlangen (Boa constrictor) auf den Kanarischen Inseln[32] und in Belgien[33] nachgewiesen. Weitere Fälle von BIBD wurden in den 2000er Jahren in verschiedenen weiteren Arten beschrieben[34]: Große Anakonda (Eunectes murinus), Gelbe Anakonda (Eunectes notaeus), Regenbogenboa (Epicrates cenchria), Haiti-Boa (Epicrates striatus), Nördliche Madagaskarboa (Acrantophis madagascariensis), Heller Tigerpython (Python molurus molurus), Netzpython (Python reticulatus) und Königspython (Python regius). Aufgrund des weltweiten Austauschs und Handels mit Riesenschlangen, was zu einer unerkannten Ausbreitung der Infektion führt, ist mittlerweile weltweit bei jeder entsprechenden Haltung der Tiere ein Auftreten der BIBD möglich. Die BIBD wurde bisher nur bei Riesenschlangen beobachtet, die in Gefangenschaft gehalten wurden. Ob diese Erkrankung auch bei freilebenden Schlangen vorkommt ist unklar.
Sehr ähnliche histologische Veränderungen mit gleichem letalem Verlauf wurden bei einer Gruppe von Marchs Palmlanzenottern (Bothriechis marchi)[35] und einer Kettennatter (Lampropeltis getula) beobachtet, wobei die eindeutige Zuordnung zur identischen oder einer nur BIBD-ähnlichen Infektionskrankheit noch aussteht. Die elektronenmikroskopische Untersuchung bei diesen Tieren zeigte eine zur BIBD abweichende Morphologie der Zelle und der Einschlusskörperchen.
Krankheitsverlauf
Klinische Symptomatik
Die Infektion ist zunächst asymptomatisch, der Ausbruch der Erkrankung nach einer wochen- oder meist monatelangen Inkubationszeit beginnt mit unspezifischen Zeichen wie Passivität, Rückzugsverhalten oder geringer Nahrungsaufnahme (Inappetenz) der Tiere. Bei Boas ist eine ständig wiederkehrende Regurgitation von Mageninhalt mehrere Tage nach der Nahrungsaufnahme oft das erste spezifischere Anzeichen einer BIBD. Ihr folgt oft eine vollständige Verweigerung der Nahrungsaufnahme (Anorexie) und manchmal eine irreguläre, häufige Häutung. Nach wenigen Wochen treten auffällige neurologische Symptome als Zeichen einer Infektion des Zentralnervensystems (ZNS) hinzu, die zusammen mit den Regurgitationen als typisch für die BIBD angesehen werden. Dazu gehören eine eingeschränkte räumliche Orientierung (Desorientiertheit), ein Tremor des Kopfes, Ataxie, schlaffe Lähmungen, untypisch verschlungene Körperhaltungen mit starrer, abgeknickter Kopfhaltung und ein Opisthotonus mit Krämpfen der Muskulatur. Sehr charakteristisch ist eine Haltung in teilweiser Rückenlage und die Unfähigkeit, sich aus einer Rückenlage wieder in die natürliche Bauchlage zu bewegen. Letzteres wird auch als klinisches Zeichen bei einer tierärztlichen Untersuchung genutzt. Die neurologischen Störungen machen es der Schlange unmöglich, ihre Beute zu erwürgen.[36] Der Tod tritt bei Boas mehrere Wochen nach dem Auftreten der ersten klinischen Erkrankungszeichen ein, teilweise aber auch erst nach Monaten.
Pythons zeigen keine Regurgitationen, jedoch häufig eine Anorexie.[37] Im Gegensatz zu Boas erscheinen die neurologischen Symptome früher und schwerer in ihrer Ausprägung. Typisch sind bei Pythons das Sternendeuterphänomen (star-gazing), bei dem der Kopf starr nach oben gerichtet ist, das Umkippen des Kopfes, einzeln auftretende Krampfanfälle und eine Lähmung der hinteren Körperhälfte.[38] Der klinische Verlauf bei Pythons ist insgesamt rascher, so dass der Tod wenige Wochen nach Erkrankungsbeginn eintritt.
Zu den neurologischen Symptomen bei allen Riesenschlangen treten als Zeichen einer virus-induzierten Immundefizienz weitere Symptome, die meist durch Koinfektion mit zusätzlichen (eventuell opportunistischen) bakteriellen und viralen Erregern verursacht werden.[39] Dazu gehören eine Pneumonie, eine ulzerierende Stomatitis (Maulfäule der Schlangen), eine nekrotisierende, multifokale Dermatitis, bakterielle Granulome in Leber und Niere und Osteophyten der Wirbelkörper.[40] Die virus-induzierte Immundefizienz zusammen mit der früheren Annahme einer retroviralen Infektion, führten zu der irreführenden populärwissenschaftlichen Bezeichnung Boa-AIDS oder Schlangen-AIDS für die BIBD. Auch Gewebswucherungen und Tumorerkrankungen werden bei einer BIBD beobachtet. So sind Sarkome der Haut und eine Leukämie bei der BIBD beobachtet worden.[41][42] Nach der Identifizierung der BIBD-assoziierten Arenaviren wurde aus dem Tumorgewebe eines Fibromyxoms einer an BIBD erkrankten Abgottschlange ein Virus isoliert, das wahrscheinlich ein Subtyp des California-Academy-of-Sciences-Virus darstellt.[43]
Laborbefunde
Bei akut infizierten Tieren in der Anfangsphase der Erkrankung können bei der Untersuchung klinisch-chemischer und hämatologischer Parameter Auffälligkeiten bestehen, die insgesamt aber nicht spezifisch für die Erkrankung und damit diagnostisch nicht wegweisend sind. Dazu gehören als allgemeine Entzündungsparameter eine Erhöhung der Leukozytenzahl im Blut (Leukozytose) und eine prozentuale Erhöhung des Lymphozytenanteils (relative Lymphozytose). Als Anzeichen für eine Beteiligung der Leber sind erniedrigte Werte für das Gesamtprotein und für die Globuline im Serum sowie erhöhte Aspartat-Aminotransferase-Konzentrationen im Serum messbar. Besonders letzteres ist bei chronischen Verläufen nicht in diesem Ausmaß zu beobachten.[44]
Diagnostik
Histologische Diagnostik

Die Diagnose einer BIBD kann durch histologische Untersuchungen von Gewebeproben, Gewebeabstrichen der Mundschleimhaut und Heparin-Vollblut gestellt werden. Bei lebenden Tieren können Leberbioptate oder Gewebeproben aus Drüsengewebe (Bauchspeicheldrüse) verwendet werden, deren Gewinnung in Vollnarkose jedoch nicht risikoarm und sehr aufwändig ist. Die ösophagealen Tonsillen sind bei Riesenschlangen gut ausgeprägt und endoskopisch für eine Biopsie leichter zugänglich.[45] Zur Beurteilung werden die fixierten und geschnittenen Gewebeproben mit der HE- oder Wright-Giemsa-Färbung angefärbt. Der mikroskopische Nachweis der typischen eosinophilen Einschlusskörperchen in Leber, Drüsengewebe, Blutlymphozyten weist auf eine BIBD hin. Nur bei Boas, nicht jedoch bei Pythons, können Einschlusskörperchen auch in Erythrozyten nachgewiesen werden und dies oft schon vor Ausbruch der Erkrankung. Zur Untersuchung wird bei Schlangen heparinisiertes Blut aus den Mundvenen oder durch Herzpunktion entnommen.[46]
Das Fehlen dieser Anzeichen bei einer Gewebe- oder Blutuntersuchung schließt eine Infektion jedoch prinzipiell nicht aus. Die Erkrankung kann durch eine Sektion toter Tiere zweifelsfrei nachgewiesen werden, wobei die typischen histologischen Anzeichen neben anderen Organen vor allem in Hirn-, Leber- und Bauchspeicheldrüsengewebe zu finden sind.
Virologische Diagnostik
Ein direkter Erregernachweis von Reptarenaviren in Gewebeabstrichen und Gewebeproben mittels PCR kann versucht werden, die Aussagekraft eines solchen Nachweises in der Praxis ist derzeit noch nicht ausreichend erprobt (Stand 2016). Der negativ prädiktive Wert einer PCR auf arenavirale RNA insbesondere bei lebenden Tieren ist noch unklar.[47]
Für Forschungszwecke kann eine Virusanzucht und Identifizierung in der Zellkultur erfolgen. Ein serologischer Test zum Nachweis spezifischer Antikörper steht für die Routinediagnostik noch nicht zur Verfügung. Antikörper gegen das in den Einschlusskörperchen überwiegend vorkommende p68-IBD-Protein erreichten in serologischen Tests bei einer Studie mit 93 Tieren eine Spezifität von 100 % und eine Sensitivität von 83 %.[48] Experimentell konnte Reptarenaviren-spezifisches Anti-IgM und Anti-IgY (dem Pendant zu IgG bei Reptilien) isoliert und zur Herstellung von Antikörpern für serologische Nachweise im Immunblot oder der direkten Immunfluoreszenztestung hergestellt werden.[49]
Differentialdiagnosen
Das klinische Bild einer Regurgitation (bei Boas) verbunden mit neurologischen Symptomen weist auf eine BIBD hin, jedoch können auch andere Erkrankungen mit ähnlichen Symptomen auftreten und kommen daher differentialdiagnostisch in Betracht.[50][51] Eine Regurgitation kann bei verschiedenen anderen Infektionskrankheiten der Schlangen beobachtet werden, so einer Infektion des Verdauungstraktes mit Amöben, Trichomonaden, Coccidien, Kryptosporidien, verschiedene Wurminfektionen mit Fadenwürmern oder einer bakteriellen Gastritis, Enteritis und Stomatitis. Erbrechen von angedauter Nahrung ist ein häufiges Symptom bei Vergiftungen. Bei einer Vergiftung mit Phosphorsäureestern, die unter anderem zur Bekämpfung der Schlangenmilben eingesetzt werden, ist das Erbrechen mit neurologischen Symptomen verbunden. Erbrechen ist bei einer Sepsis, einer Tumorerkrankung, einer zu hohen Umgebungstemperatur oder als Folge einer Gewalteinwirkung durch falsche Handhabung der Tiere ein häufiges Symptom. Die neurologischen Symptome treten auch bei einer Enzephalitis viraler, bakterieller oder parasitärer Genese auf. Die wichtigsten Differentialdiagnosen sind eine Infektion mit Paramyxoviren (Schlangen-Paramyxoviren ATCC-VR-1408 und -1409), die neurologische und respiratorische Symptome aufweisen kann, sowie Krampfanfälle kombiniert mit gastrointestinalen Symptomen bei einer invasiven Infektion mit Entamoeba invadens oder Acanthamoeba-Arten.
Therapie und Prophylaxe
Eine spezifische antivirale Therapie gegen Reptarenaviren ist nicht verfügbar, eine symptomatische Behandlung der neurologischen Störungen ist ebenfalls nicht möglich. Die aktive Fütterung der nicht mehr selbständig zur Nahrungsaufnahme fähigen Tiere und eine Zuführung von Flüssigkeit kann in einigen Fällen den Allgemeinzustand verbessern, ein Fortschreiten der Infektion wird dadurch nicht beeinflusst.[52] Bei erkrankten Tieren mit einer eindeutigen histologischen Diagnose wird eine Tötung empfohlen, die bei Schlangen mit der intrakardialen oder intrazölomatischen Gabe von Pentobarbital oder T61 durchgeführt werden kann.[53] Die Tötung verhindert ein langsames Verhungern durch die bei der BIBD auftretenden neurologischen Lähmungen. Infizierte, aber noch nicht erkrankte Boas, können unter strikter Isolation gehalten werden. Da auch eine Impfung als Dispositionsprophylaxe nicht zur Verfügung steht, beschränken sich die Maßnahmen auf die Eindämmung der Weiterverbreitung der Infektion im Sinne einer Expositionsprophylaxe. Dies sind eine hygienische Tierhaltung mit Desinfektion der Kontaktoberflächen, der Geräte (Fangzangen) und der Hände nach Kontakt mit dem Tier und insgesamt saubere Haltungsbedingungen. Da die Reptarenaviren eine Virushülle besitzen, genügen Desinfektionsmittel mit begrenzter Viruzidie. Diese Maßnahmen mindern zusätzlich das Risiko für einen Befall mit Schlangenmilben, die als mögliche Überträger der BIBD noch nicht ausgeschlossen werden können.
Vor Einbringung eines neuen Tieres in eine gemeinsame Haltung ist – unabhängig von einer diagnostizierten Erkrankung oder einer Herkunft aus einer vorgeblich BIBD-freien Zucht – eine strikte Quarantäne von minimal drei bis besser sechs Monaten einzuhalten, wobei bei Boas aufgrund der langsameren Krankheitsentwicklung stets sechs Monate empfohlen werden.[54] Eine Quarantäne von sechs Monaten bietet einen als ausreichend angesehenen Sicherheitszeitraum bei der sehr variablen Inkubationszeit.
Literatur
- J. Schumacher et al.: Inclusion Body disease in Boid Snakes. Journal of Zoo and Wildlife Medicine (1994) 25, 4: S. 511–524
- Petra Kölle (Hrsg.): Heimtier und Patient: Echsen und Schlangen. Stuttgart (Enke) 2015, S. 215 f., ISBN 978-3-83-041224-3
- D. Vancraeynest et al.: Inclusion body disease in snakes: a review and description of three cases in boa constrictors in Belgium. Vet. Rec. (2006) 158(22): S. 757–760, PMID 16751310
- L-W. Chang und E.R. Jacobson: Inclusion Body Disease, A Worldwide Infectious Disease of Boid Snakes: A Review. Journal of Exotic Pet Medicine (2010) 19(3): S. 216–225 (PDF)
Weblinks
- Abbildungen auf Researchgate (aus: L-W. Chang und E.R. Jacobson, 2010)
- The Joint Pathology Center (Silver Spring, Maryland, USA) Fallbeschreibungen mit vollständigen histologischen Präparaten:
- Slide Conference Nr. 11, 2012: Fallbeschreibung mit Präparat eines Blutausstrichs, Boa constrictor imperator mit BIBD
- Slide Conference Nr. 24, 2009: Fallbeschreibung und mikroskopisches Präparate (Leber) einer erkrankten Boa constrictor
Einzelnachweise
- ↑ J. Schumacher et al. (1994)
- ↑ M. K. Axthelm: Clinicopathologic and virologic observations of a probable viral disease affecting boid snakes. Proc. Annu. Meet. Am. Assoc. Zoo Vet. (1985): S. 108–109 (Abstract)
- ↑ J. Schumacher et al. 1994, S. 511
- ↑ L.-W. Chang und E. R. Jacobson, 2010, S. 218
- ↑ E. R. Jacobson und D. A. Samuelson: Identifying reptil pathogens using electron microscopy. In: E. R. Jacobson (Hrsg.): Infectious Diseases and Pathology of Reptiles: A Color Altlas and Text, CRC Press, Boca Raton, 2007, ISBN 978-0-84-932321-8, S. 299 ff
- ↑ a b E. Wozniak et al.: Isolation and characterization of an antigenically distinct 68-kd protein from nonviral intracytoplasmic inclusions in Boa constrictors chronically infected with the inclusion body disease virus (IBDV: Retroviridae). Veterinary Pathology (2000) 37(5): S. 449–459, PMID 11055868.
- ↑ L.-W. Chang et al.: Immunohistochemical detection of a unique protein within cells of snakes having inclusion body disease, a world-wide disease seen in members of the families Boidae and Pythonidae. PLoS One (2013) 8 (12), PMID 24340066.
- ↑ J. Schumacher et al.: Inclusion Body disease in Boid Snakes. Journal of Zoo and Wildlife Medicine (1994) 25, 4: S. 511–524
- ↑ J. B. Huder et al.: Identification and characterization of two closely related unclassifiable endogenous retroviruses in pythons (Python molurus and Python curtus). J. Virol. (2002) 76(15): S. 7607–7615, PMID 12097574.
- ↑ E. Herniou et al.: Retroviral diversity and distribution in vertebrates. J. Virol. (1998) 72(7): S. 5955–5966, PMID 9621058.
- ↑ M. D. Stenglein et al.: Identification, characterization, and in vitro culture of highly divergent arenaviruses from boa constrictors and annulated tree boas: candidate etiological agents for snake inclusion body disease. MBio. (2012) 3 (4):e00180-12, PMID 22893382.
- ↑ a b U. Hetzel et al.: Isolation, identification, and characterization of novel arenaviruses, the etiological agents of boid inclusion body disease. J. Virol. (2013) 87 (20): S. 10918–10935, PMID 23926354.
- ↑ R. Bodewes et al.: Detection of novel divergent arenaviruses in boid snakes with inclusion body disease in The Netherlands. J. Gen. Virol. (2013) 94 (6): S. 1206–1210, PMID 23468423.
- ↑ S. R. Radoshitzky et al.: Past, present, and future of arenavirus taxonomy. Arch. Virol. (2015) 160 (7): S. 1851–1874, PMID 25935216.
- ↑ N. L. Baird et al.: Arenavirus infection induces discrete cytosolic structures for RNA replication. J. Virol. (2012) 86 (20): S. 11301–11310, PMID 22875974.
- ↑ J. Hepojoki et al.: Arenavirus Coinfections Are Common in Snakes with Boid Inclusion Body Disease. J. Virol. (2015) 89 (16): S. 8657–8660, PMID 26041290.
- ↑ U. Hetzel et al.: Reply to "Updated phylogenetic analysis of arenaviruses detected in boid snakes". J. Virol. (2014) 88 (2): S. 1401, PMID 24379419.
- ↑ M. D. Stenglein et al.: Widespread recombination, reassortment, and transmission of unbalanced compound viral genotypes in natural arenavirus infections. PLoS Pathog. (2015) 11 (5): e1004900, PMID 25993603.
- ↑ Elliott R. Jacobson: Snake Inclusion Body Disease. (reptilesmagazine.com)
- ↑ L. P. Villareal: Evolution of Viruses. In: Brian W. J. Mahy und Marc H. van Regenmortel (Hrsg.): Encyclopedia of Virology, 3. Auflage, San Diego 2008, Band 2, ISBN 978-0-12-373935-3, S. 174–184
- ↑ Stephen S. Morse: Examining the Origins of Emerging Viruses (Abschnitt: Emergence as a two-step Process, And the Importance of Viral Traffic). In: Stephen S. Morse (Hrsg.): Emerging Viruses. Oxford University Press 1993, ISBN 0-19-507444-0, S. 16–20
- ↑ J. Ter Meulen et al.: Hunting of peridomestic rodents and consumption of their meat as possible risk factors for rodent-to-human transmission of Lassa virus in the Republic of Guinea. American J. Trop. Med. Hyg. (1996) 55(6): S. 661–666, PMID 9025695.
- ↑ J. Hepojoki et al.: Replication of boid inclusion body disease-associated arenaviruses is temperature sensitive in both boid and mammalian cells. J. Virol. (2015) 89 (2): S. 1119–1128, PMID 25378485.
- ↑ M. D. Stenglein et al.: Widespread recombination, reassortment, and transmission of unbalanced compound viral genotypes in natural arenavirus infections. PLoS Pathog. (2015) 11 (5): e1004900, PMID 25993603.
- ↑ J. Schumacher et al., 1994
- ↑ D. Vancraeynest et al., 2006, S. 757
- ↑ Petra Kölle (Hrsg.): Heimtier und Patient: Echsen und Schlangen. Stuttgart (Enke) 2015 S. 215
- ↑ M. M. Garner, J. T. Raymond: Methods for diagnosing inclusion body disease in snakes. Proc. of the Association of Reptile and Amphibian Veterinarians Congress, Naples USA, 8. bis 11. Mai 2004, S. 21–25. Zitiert nach: D. Vancraeynest et al.: Inclusion body disease in snakes: a review and description of three cases in boa constrictors in Belgium. Vet. Rec. (2006) 158 (22): S. 758, PMID 16751310.
- ↑ Petra Kölle (Hrsg.): Heimtier und Patient: Echsen und Schlangen. Stuttgart (Enke) 2015 S. 215
- ↑ M. Pees et al.: Prevalence of viral infections in captive collections of boid snakes in Germany. Veterinary Recorded (2010) 166 (14): S. 422–425, PMID 20364009.
- ↑ M. S. Carlisle-Nowak et al.: Inclusion body disease in two captive Australian pythons (Morelia spilota variegata and Morelia spilota spilota). Aust. Vet. J. (1998) 76 (2): S. 98–100, PMID 9578777.
- ↑ J. Orós et al.: Inclusion body disease in two captive boas in the Canary islands. Vet. Rec. (1998) 143 (10): S. 283–285, PMID 9787424.
- ↑ D. Vancraeynest et al.: Inclusion body disease in snakes: a review and description of three cases in boa constrictors in Belgium. Vet. Rec. (2006) 158 (22): S. 757–760, PMID 16751310.
- ↑ L-W. Chang und E.R. Jacobson: Inclusion Body Disease, A Worldwide Infectious Disease of Boid Snakes: A Review. Journal of Exotic Pet Medicine (2010) 19 (3): S. 217
- ↑ J. T. Raymond et al.: A disease resembling inclusion body disease of boid snakes in captive palm vipers (Bothriechis marchi). J. Vet. Diagn. Invest. (2001) 13 (1): S. 82–86, PMID 11243371.
- ↑ R. Avery Bennett: Neurology. In: Douglas R. Mader (Hrsg.): Reptile Medicine and Surgery. Philadelphia (Saunders) 2. Auflage 2005, ISBN 978-0-72-169327-9, S. 239–250
- ↑ J. Schumacher et al. (1994) S. 513
- ↑ M. S. Carlisle-Nowak et al.: Inclusion body disease in two captive Australian pythons (Morelia spilota variegata and Morelia spilota spilota). Aust. Vet. J. (1998) 76(2): S. 98–100, PMID 9578777.
- ↑ J. Orós et al.: Inclusion body disease in two captive boas in the Canary islands. Vet. Rec. (1998) 143(10): S. 283–285, PMID 9787424.
- ↑ P. Zwart, U. Hetzel und K. J. Dik: Osteitis deformans and concomitant inclusion body disease in a boa (Boa constrictor). Verhandlungsbericht Erkrankungen der Zootiere (2001) 40: S. 61–66
- ↑ J. Schumacher et al. (1994) S. 513 f
- ↑ R. E. Marschang: Viruses infecting reptiles. Viruses (2011) 3(11): S. 2087–2126, PMID 22163336.
- ↑ T. Hellebuyck et al.: Detection of arenavirus in a peripheral odontogenic fibromyxoma in a red tail boa (Boa constrictor constrictor) with inclusion body disease. J. Vet. Diagn. Invest. (2015) 27 (2): S. 245–248, PMID 25776548.
- ↑ J. Schumacher et al., 1994
- ↑ L.-W. Chang et al. 2010, S. 220
- ↑ P. Zwart: Schlangen. In: K. Gabrisch, P. Zwart (Hrsg.): Krankheiten der Heimtiere, Hannover (Schlütersche) 3. Auflage 1995, S. 762 ISBN 387706325X
- ↑ T. Aqrawi et al.: Identification of snake arenaviruses in live boas and pythons in a zoo in Germany. In: Tierärztliche Praxis Kleintiere (2015) 43(4): S. 239–247, PMID 26109078.
- ↑ L.-W. Chang et al.: Immunohistochemical detection of a unique protein within cells of snakes having inclusion body disease, a world-wide disease seen in members of the families Boidae and Pythonidae. PLoS One (2013) 8 (12), PMID 24340066.
- ↑ Y. Korzyukov et al.: Generation of Anti-Boa Immunoglobulin Antibodies for Serodiagnostic Applications, and Their Use to Detect Anti-Reptarenavirus Antibodies in Boa Constrictor. PLoS One (2016) 11(6):e0158417, PMID 27355360.
- ↑ R. S. Funk: Differential Diagnoses by Symptoms. Snakes. In: D. R. Mader (Hrsg.): Reptile Medicine and Surgery, Philadelphia (W. R. Saunders) 2. Auflage 2005, ISBN 978-0-72-169327-9, S. 405 und 675 f
- ↑ P. Zwart: Schlangen. In: K. Gabrisch, P. Zwart (Hrsg.): Krankheiten der Heimtiere, Hannover (Schlütersche) 3. Auflage 1995, S. 764 f und 785–788 ISBN 387706325X
- ↑ D. Vancraeynest et al. 2006, S. 759
- ↑ P. Zwart: Schlangen. In: K. Gabrisch, P. Zwart (Hrsg.): Krankheiten der Heimtiere, Hannover (Schlütersche) 3. Auflage 1995, S. 763 ISBN 387706325X
- ↑ EAZWV Transmissible Disease Fact Sheet Nr. 34, Empfehlung der European Association of Zoo and Wildlife Veterinarians, Stand 2009 (pdf)